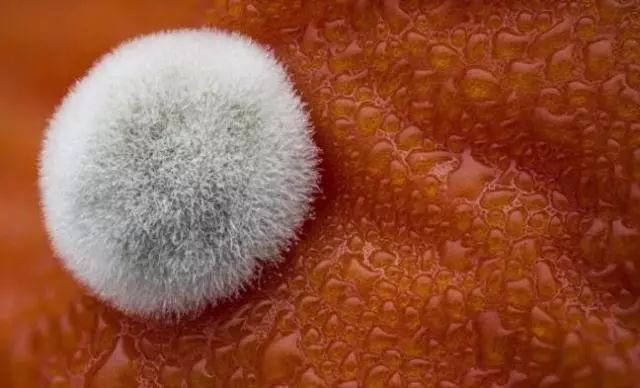

特殊的儿童节礼物,成人看了都尖叫:我酸了,我也要过节!!
2021年06月02日

1425阅读
31赞
普象好用
写下你的想法